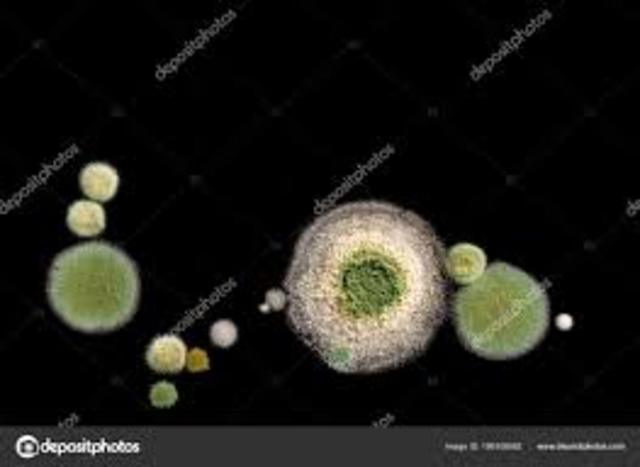
Período de la macrociencia

-
Forma de recoger la producción científica
-
El filósofo británico Francis Bacon publicó su libro que planteó que la ciencia da al ser humano el dominio sobre la naturaleza
-
El uso de carbon mineral en Inglaterra
-
Máquina de Vapor en la industria y transporte
(J Watt) -
Forma de Obtener tejidos mecanizada
-
Revolución del transporte
-
Transporte de pasajeros en una locomotora
-
Inicio de la comunicación masiva
-
Hito que revolucionaría la industria de la construcción
-
La vida en virtud de las refinerías de crudo y su influencia en el mundo
-
Evento marcante del desarrollo del mundo moderno
-
Hito que marca las comunicaciones
-
Definitivamente junto con los combustibles cambiaría la historia
-
REGISTRO DE ACTIVIDADES EN IMÁGENES EN MOVIMIENTO
-
Un evento que cambia el rumbo de la historia
-
Las comunicaciones en función del desarrollo
-
Comunicación en movimiento domiciliar
-
Ciencia y tecnología
-
Ciencia para el bién de la humanidad
-
Big Science que se inició en la década de los años
30 y se extendió hasta finales de los 50 -
Comunicaciones y Ciencia
-
Un período de crisis desde los años 60 hasta mediados de los 70
-
Libro de Thomas Samuel Kuhn describe cómo
ocurren los cambios científicos -
Se inició en los 70 y se extiende hasta la actualidad.
-
Un antes y un después en las comunicaciones y la tecnología
A list shows items. A timeline shows sequence.
Use Timetoast to make dates, milestones, and turning points easier to understand in a clear visual format. Timetoast is a timeline maker for work, school, research, and stories.